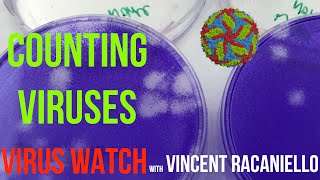

Introduction to cell culture, splitting cells using trypsin and counting them using a hemocytometer
101.01k views1761 WordsCopy TextShare

Dr Germán Rosas-Acosta
This video provides you with a general overview of the procedures typically used to "spit" a culture...
Video Transcript:
cell culture is a method in which tissue or cells are grown artificially outside of their native environment this artificial environment contains all necessary nutrients and conditions to allow cells to grow and proliferate cell culture is especially important because it provides excellent and clinically relevant models to study cellular physiology and biochemistry in addition cell culture has many applications including vaccine development and screening drugs and compounds which we will be doing in this laboratory cell cultures can be derived from either primary tissue explants or cell suspensions primary cell cultures typically will have a finite life span and
culture whereas immortalized cell lines are by definition abnormal and can reproduce indefinitely this can often be achieved by transforming cells in order to acquire these properties in order to optimally culture and preserve the integrity of cells several physiological conditions must be met such as appropriate temperature and gas mixture these two are normally said as 37 degrees celsius and 5 co2 mammalian cells also require a humidified environment all of these parameters can be met and controlled using a cell incubator aside from temperature and gas mixture another factor that varies in culture systems is the cell growth
medium media requirements vary by cell line but medias are typically composed of the following glucose or glutamine which serve as a source of energy amino acids which are the building blocks of proteins vitamins to promote cell survival and growth a balance of ions in solution to maintain osmotic pressure within the cells bicarbonate buffer to maintain a balanced ph and growth factors a lot of the nutrients that supplement media are often derived from the serum of animal blood such as fetal bovine serum fps is an important source of nutrients in media since it provides growth factors
and hormones in a variety of small molecules like amino acids sugars and lipids equally as important to these essential materials cell culture and requires additional reagents phosphate buffered saline or pbs is used in cell culture in order to wash cells since we will be working with adherent cells pbs will be used to rinse the cell monolayer to remove residual media with fps before passaging pbs is also important because it maintains physiological ph and osmolarity which helps keep our cells alive during the wash process trypsin is a proteolytic enzyme also known as a protease its function
in cell culture is to break down proteins that help adherent cells attached to the surface of the flask most strips and solutions for cell culture also contain edta which is a chelating agent that helps remove calcium and magnesium in order to enhance cell dissociation tribe and blue helps us distinguish between dead cells and living cells by passing through the damaged membranes of dead cells this is typically used alongside a hemocytometer which is a glass counting chamber with a laser etched grid onto which a glass coverslip is mounted a non-volume with trapping blue with cells can
then be loaded under the glass and counted if you refer back to your manual you will see that there are three human cancer cells that are mentioned for today's and any upcoming videos we will be working with a different cell line called 22 rv ones this is an adherent cell line derived from a human prostate carcinoma that preferentially grows in rpmi medium supplemented with 10 fps today we will learn about passaging ourselves this is also known as subculturing or the transfer of cells from a previous culture into fresh growth medium to allow the saline to
further grow adherent cells should be passage when the cells become semi-confluent confluence refers to the percentage of the surface that is covered by adherent cells a 50 confluence means that the cells are covering half of the entire surface of the plate ideally cells should be passage when they reach a 70 to 80 percent confluence and while they are still in the exponential growth phase cells will initially go through a coisin or like phase at this stage the cells do not divide the cells will then go into exponential growth where they have the highest metabolic activity
eventually the cells will enter stationary phase where the cell number is constant and the cells have reached confluence now let's begin passaging ourselves cell cultures should be carried out in a laminar flow safety cabinet located in a room that is specific to cell culture please refer back to your manual for more information on cell culturing hoods it is important to use a septic technique in order to prevent contamination of cell culture and reagents from microorganisms in the environment for this reason we should always spray the interior of the hood with 70 ethanol before beginning we
should also spray all reagents and materials with 70 ethanol before taking them into the hood we will now take our cell culture flask out of the incubator and into the laminar flow hood gloved hands should also be sprayed with 70 ethanol before entering the hood since we are working with the liquid cell culture we will be generating liquid waste therefore we have set up a vacuum flask inside of the hood containing bleach this way we can aspirate any liquid waste for proper disposal first we begin by removing and discarding the spent culture media from the
culture vessel it is important to replace a cap on our flask and our bottles quickly in order to decrease the chances of contamination next we will be washing ourselves using a balanced cell solution such as pbs we will be using four to five mls to rinse ourselves this volume will vary depending on how big or small you sell culture flask is it is important to add this solution and any other solution to the side of the flask that is opposite of the site in which the cells are attached this is in order to avoid disturbing
the cell monolayer we will now rock the flask back and forth in order to cover and rinse the entire surface we then aspirate the first wash and continue with the second wash it is important to move quickly and to add the neck solution as quick as possible in order to prevent the cells from drying and causing cell damage we add the pre-warmed trypsin to the side of the floss in order to detach the cells from the plate the volume of this reagent will also vary depending on the surface area to be covered we will use
just enough trypsin to cover the cell layer shape in this case we will be using one milliliter the flask will then be incubated at 37 degrees celsius for approximately three minutes different cell lines will require different incubation times it is important to observe the cells under a microscope in order to confirm that the cells are being released cells that have been detached will also slide if you tilt the flask here we are labeling our conical tube with the name of the cell line it is important to label all of the flask with the name of
the selling the passage number the date and your name now that most of the cells have detached from the surface we will proceed to neutralize or inactivate the trypsin using fbs containing media aside from being nutrient rich fps also contains protease inhibitors and because trypsin is a protease the fps will help us inhibit its activity this time we are adding the media directly on the side of the flask that contains the cells the purpose of this is to loosen any cells that have not completely detached and to collect all the cells at the bottom of
the flask we can now transfer the cell suspension into our labeled 15ml conical tube from our cell suspension we will now set aside 10 microliters in order to dilute with tripe and blue our dilution factor for this suspension will be 10 since we will be adding 10 microliters of the cells to 90 microliters of tripod blue here we use a 96 well plate in order to mix our tribe and blue with the cells once the solution of cells and trapping blue has been mixed we will aliquot 10 microliters into the chamber of a hemocytometer this
is simply done by releasing the liquid onto the edge of the hemocytometer the liquid will move into the chamber through capillary action in between the glass and the hemocytometer we are now ready to count ourselves under the microscope we can also centrifuge our conical tube in order to pellet the cells and remove the media that contains the neutralized trypsin so now let's count ourselves remember that the hemocytometer has laser etched grids the two grids are composed of nine large squares in order to counter cells we'll be focusing on the four corner squares each of these
squares measures one millimeter by one millimeter or one millimeter squared when we place a glass coverslip on top of the hemocytometer each of these squares can contain up to 100 nanoliters which is equal to 0.1 microliters of cell suspension so let's load our hemocytometer with cells and count only the four corner squares this is a formula we will be using to calculate the number of cells we have this formula calculates the number of cells per one milliliter this means that we have to multiply by the number of mls in order to calculate the total number
of cells you may be wondering why we multiply by 10 to the fourth this is because each of the large squares holds 0.1 microliters and we are trying to calculate the number of cells in one ml or one thousand microliters so we multiply by ten thousand once we count the cells in the four corner squares we calculate the average then we multiply by our dilution factor of 10. remember we added 10 microliters of cells to 90 microliters of tripoli then we multiply our number by 10 000 or 10 to the fourth in order to calculate
the number of cells in one ml so here we see our total number of cells per ml is 2.3 million we can now multiply by the total volume in order to get the total number of cells you have now learned the basics in cell culturing and cell counting you will be using these skills in the next few experiments
Related Videos

23:37
Mammalian cell culture
Neil Cross
99,811 views

58:07
Real-Time PCR in Action
USDA Animal and Plant Health Inspection Service
286,682 views

5:50
Splitting cells: Why It’s Important and 3 ...
Cell Signaling Technology, Inc.
5,433 views

58:44
Mastering basic cell culture techniques
Labroots
14,884 views

9:31
Counting cells on a hemocytometer
BIOM3014 Laboratory Practical - UQ
91,467 views
9:48
Virus Watch: Counting Viruses
MicrobeTV
66,825 views

12:00
🔬 ESSENTIAL CALCULATIONS FOR CELL CULTURE...
Adwoa
624 views

11:58
MDMA synthesis in 3 steps & how it could h...
Total Synthesis
179,043 views

17:35
How a quartz watch works - its heart beats...
Steve Mould
7,436,192 views

5:50
Tissue Culture Series #1: How to Thaw Cell...
MilliporeSigma
12,149 views

16:49
Introduction to Cell Culture
The Ahmed Lab: Northwestern Neurosurgery
9,360 views

10:26
Cell Culture Contamination and Quality Con...
Applied Biological Materials - abm
15,971 views

23:13
The Science Of Foam
New Mind
344,574 views

20:04
A Grape Made of... Meat?? - Tissue Recellu...
The Thought Emporium
9,855,306 views

6:31
Counting Cells with a Hemocytometer
BioNetwork
1,351,749 views

25:43
MTT Assay for Cell Viability
The Ahmed Lab: Northwestern Neurosurgery
97,099 views

5:31
Subculture of Adherent Cells
Abnova
96,804 views

4:34
Cell Culture: Cell Culture Basics
Thermo Fisher Scientific
421,527 views

4:08
7. Counting of cells using Trypan Blue an...
ECACC
104,277 views

22:05
DIY Scanning Laser Microscope
Breaking Taps
429,421 views